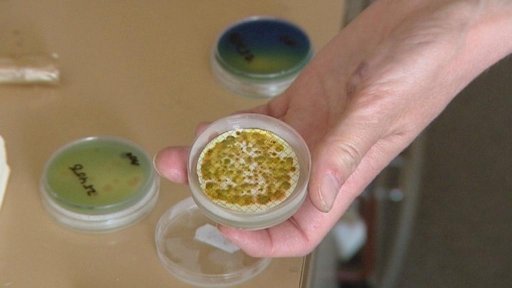
Některá přírodní koupaliště znečišťuje voda ze záplav

18. června 2013
Obsah dílu
Teplé počasí uvítali lidé v zatopených obcích — Mělník zvažuje, jak vylepšit novou hráz — Děčín spočítal předběžné škody po povodních na 420 milionů — V Černousích na Frýdlantsku chybějí odvodňovací kanály — Vodohospodáři v Českém Krumlově vytáhli z Vltavy most stržený povodní — Teplotní rekordy — Některá přírodní koupaliště znečišťuje voda ze záplav — Lidé se v Praze koupou i přes zákaz hygieniků — Provozovatelé koupališť na Vysočině letos otevřeli kvůli špatnému počasí s měsíčním zpožděním — Komplikace na D1 — V Krkonoších se ještě drží sníh — Na opravu kladrubského hřebčína ministerstvo vypíše už třetí tendr — ČSSD podpoří menšinovou vládu TOP 09 v Praze — Jihočeský a Královéhradecký kraj sloučily svá zastoupení v Bruselu — Stěhování hokejistů — V Liberci začal festival loutkářských souborů Mateřinka — Hvězdy na MFF KV — Evropští poslanci si osladili život originální českou čokoládou
Části dílu

Přehled dílů

9. ledna

8. ledna
Další možné zdržení stavby metra D — Soud potvrdil devět let za vraždu prodavaček — V Havlíčkově Brodě dnes ráno vykolejil cisternový nákladní vlak — Řešení výpadků dopravy na trati mezi Prahou a Ústím nad Labem — 20 let sporů o teplovodní síť v Chodově — V Plzni explodoval horkovod — Za tři týdny odstartuje Jizerská padesátka — Kladno nabízí lidem bez domova přístřešky — Autoservisy mají kvůli mrazu více práce — Výpověď z nájmu takzvaných kobek na pražské náplavce byla neoprávněná — Záchrana seniora pomocí dronu s termokamerou — Nedostatek psychologů na školách — Lední windskating na přehradě Blatnička — Mrazy pomáhají ale i škodí rybářům — Rekonstrukce katedrály sv. Bartoloměje v Plzni

7. ledna
Dálnice D6 by měla být hotová do 3 let — Problémy při evakuaci lidí z nákupního centra — Mráz zastavil provoz přívozů na Lipně — Jaderné elektrárny přešly na zimní provoz — Pražským kriminalistům se podařilo chytit kapsáře — Historické nádražní budovy na prodej — Rodina zachránila venkovskou památku — V půlce ledna začnou zápisy do prvních tříd — Svoz vánočních stromků — V Praze skončili adventní trhy — Poslední jízda vánočních vozů MHD v Praze — Řidiči čtyřkolek zničili na Šumavě stopy pro běžkaře — Pražský Dvorecký most by mohl dostat nové jméno — Do bílé stopy vyrážejí i hydrologové — Mráz omezuje aktivity dětí i seniorů — Ledopád láká turisty do Terčina údolí

6. ledna
Mrazy zpomalují práce na dálnicích — Česko má za sebou další arktickou noc — Poškozené vodoměry kvůli mrazu na jihu Čech — Havárie horkovodu v Praze — Několik lidí se propadlo ledem na Kladensku — Malí skláři mají problémy s rostoucími náklady — Kasína v Plzni zůstávají i přes zákaz otevřená — Hokejoví junioři získali stříbro na MS — Rodiny fandili stříbrným hokejistům — Dětská pohotovost v Klatovské nemocnici se po roce a půl vrací do normálního režimu — Pardubický kraj mění dětské domovy na rodiny — Hasiči zachránili muže, kterého škrtila krajta — V Perštejně u Chomutova je teď umělý ovál pro běžkaře — ČT uvede novou řadu seriálu Modrá krev

5. ledna
Problémy s financováním nepedagogů ve školách — Financování nepedagogů v soukromých školách — Kraje ruší slevy zavedené před volbami — V Libereckém kraji zdražila voda — Míň spojů městské hromadné dopravy v Praze — Do Česka dorazily silné mrazy — Pomoc lidem bez domova v mrazech — Péče o zvířata v mrazivém počasí — Aviatická pouť Jana Kašpara se přesune do Hradce Králové — Zájem o výběr hotovosti na České poště — Ve Zvýkovském Podhradí budou mít opět prodejnu — Záchrana hřbitova sudetských Němců — Tříkrálová sbírka pokračuje — Nové běžkařské stopy na Náchodsku

2. ledna
Provoz online pohotovosti přes svátky — Omezování návštěv v nemocnicích — Ministerstvo zdravotnictví spustilo první verze projektů elektronického zdravotnictví — V Kroměříži hořel rodinný dům — Poničená lanovka na Kleť — Záchrana lyžaře na Ještědu — Jaroměř zrušila placené parkování v centru — Hlavní tah z Tanvaldu do Polska je pro nákladní auta nad 3,5 tuny nadále neprůjezdný — Omezení na křížení dálnic D1 a D2 — Zemětřesení v Karlovarském kraji — Monitoring zvěře v zimě — Soud o havarovaném vrtulníku bude pokračovat — S novým rokem začal v Praze platit zákaz sdílených elektrokoloběžek — Pardubice znovu plánují sdílená kola — V nejvyšších polohách Šumavy napadlo od rána až patnáct centimetrů nového sněhu — Rolbaři v Krušných horách začali s úpravou běžeckých stop — Začala Tříkrálová sbírka

30. prosince 2025
Nová pravidla pro používání pyrotechniky — Vymáhání pokut za odpalování pyrotechniky — Sloučení nemocnice Motol a Na Homolce — Další ohnisko ptačí chřipky v Habrech na Havlíčkobrodsku — Ústí nad Labem navýší počty strážníků — Méně problémů ve vyloučených lokalitách v Mostě — V Krpech na Mladoboleslavsku shořela dílna s garáží — Ubývá zábran proti vzniku sněhových jazyků — Vlci zabili 36 ovcí na Broumovsku — V Liberci se znovu uzavřel městský zimní stadion Svijanská aréna — Lidem bez domova nabízí nocleh a ošetření — Náročná záchrana patnáctileté dívky na Pelhřimovsku — Strážcy NP Šumava posilují hlídky — Národní park České Švýcarsko pokračuje v odstraňování naplavených kmenů z řeky Kamenice — Nové Technické muzeum ve Vysokém Mýtě — Letošní poslední nostalgická jízda zubačky — V pražské zoo se narodilo mládě tučňáka Humboldtova

29. prosince 2025
Zdražení jízdenek v Praze a středních Čechách — Zdražení jízdného v dalších krajích — Spojení liberecké nemocnice s českolipskou — Omezení při návštěvách v nemocnicích — Poslední šance podat žádost o superdávku — Bezpečnost v mrazivém počasí — Zloději o víkendu ukradli v Praze tři auta kurýrů — Kontroly prodeje zábavní pyrotechniky — Rozšíření obchvatu Jihlavy — Doparvní stavby ve středních Čechách na příští rok — Třídicí linky jedou naplno — Oprava KD Slavie bude stát minimálně 900 milionů — Horské túry v Krkonoších jen s potřebnou výbavou — Na Šumavě znovu mrzne, střediska opět vyrábí technický sníh — Speciální zimní prohlídky na hradě Kašperk

23. prosince 2025
Dopravci před Vánoci posílili spoje — Posílené dopravní spoje před Vánocemi — Obvinění muže z krádeže kabelů na železnici — Likvidace chovu drůbeže na Havlíčkobrodsku — Záchrana ženy z kolejiště metra — Skládka v Bystrém je na hranici kapacity — Dopravní nehody pod vlivem alkoholu — Pátrání po řidiči — Auta bez povinného ručení — Příběh seniora bez domova spustil vlnu pomoci — Betlémské světlo v Hradci Králové — Česko čeká ochlazení i sníh — Lyžování o Vánocích v Krušných horách — Vánoční pochůzky s ponocným — Kostely se připravují na půlnoční mši — Česká mše vánoční rozezněla prostory huti Barbora v Jincích u Prahy

22. prosince 2025
Chřipková epidemie v Česku neustupuje — Klauni zpříjemňují Vánoce dětem v nemocnici — Vyšetřování krádeže kabelů na trati v Praze — Problémy na trati Praha–Ústí nad Labem — Osobní vlaky mezi Ústím nad Labem a Děčínem přestanou jezdit po pravém břehu Labe — Vodárny v Pardubicích potřebují investice — Dálkové odečty vodoměru v Českých Budějovicích — Požár bytu v Mostě — 7 zraněných po požáru v Ruprechticích — Na Vysočině se opět objevila ptačí chřipka — Předvánoční nákupy za hranicemi — Biblický příběh ožívá na Čertovce — Nový exponát v leteckém muzeu v Kunovicích — Nové sochy v Bezděkově nad Metují — Rozdávání Betlémského světla



